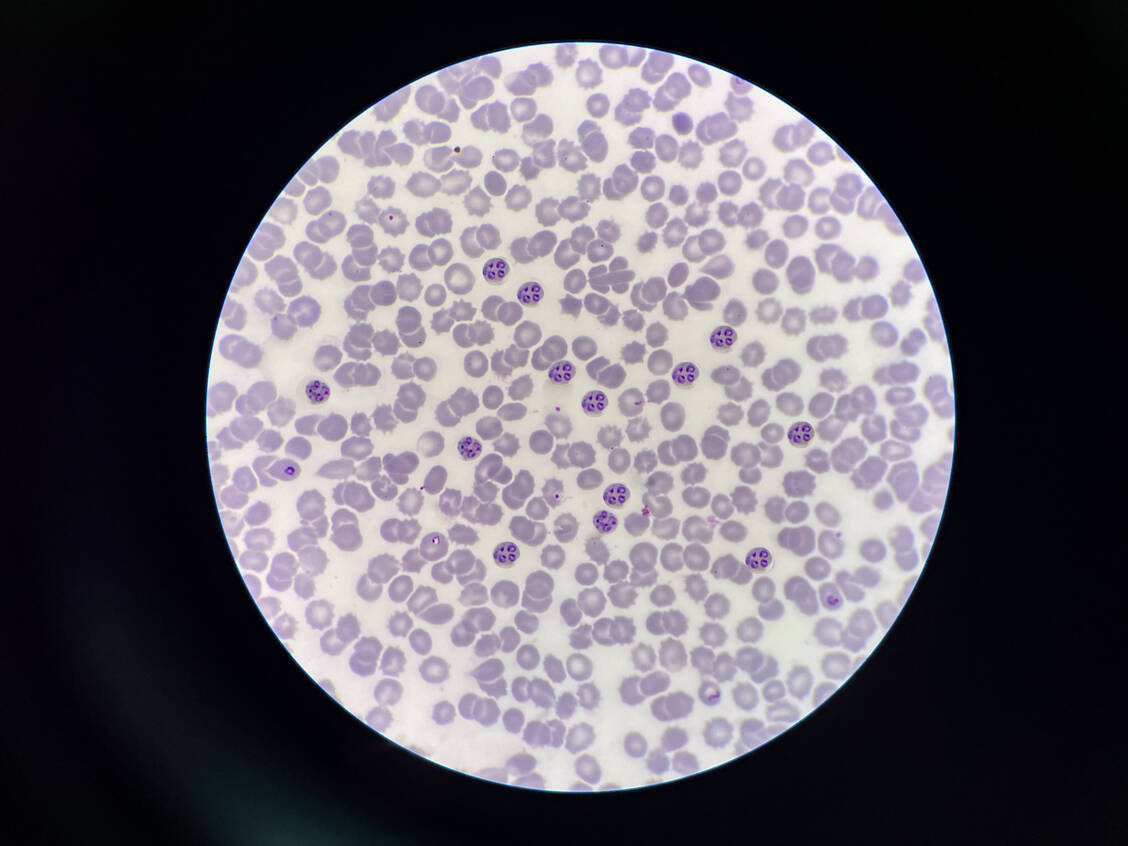

Als Wirkmechanismus wird angenommen, dass nach der eisenvermittelten Spaltung des Peroxids ein freies Radikal entsteht, das an Proteine des Malariaerregers bindet und letztlich die Membran des Parasiten schädigt. Hierzu trägt wahrscheinlich bei, dass sich DHA stark in Erythrozyten anreichert, die mit Plasmodien infiziert sind (300-fach höhere Konzentration als im Plasma). Laut In-vitro-Daten wirkt Artesunat gegen alle Plasmodien-Arten, die beim Menschen Malaria verursachen, ähnlich gut. Dies sind neben P. falciparum, dem Erreger der Malaria tropica, P. vivax, P. ovale, P. malariae und P. knowlesi. Allerdings ist Artesunat gegen die von P. vivax und P. ovale gebildeten Leber-Ruhestadien (Hypnozoiten) des Erregers nicht wirksam.